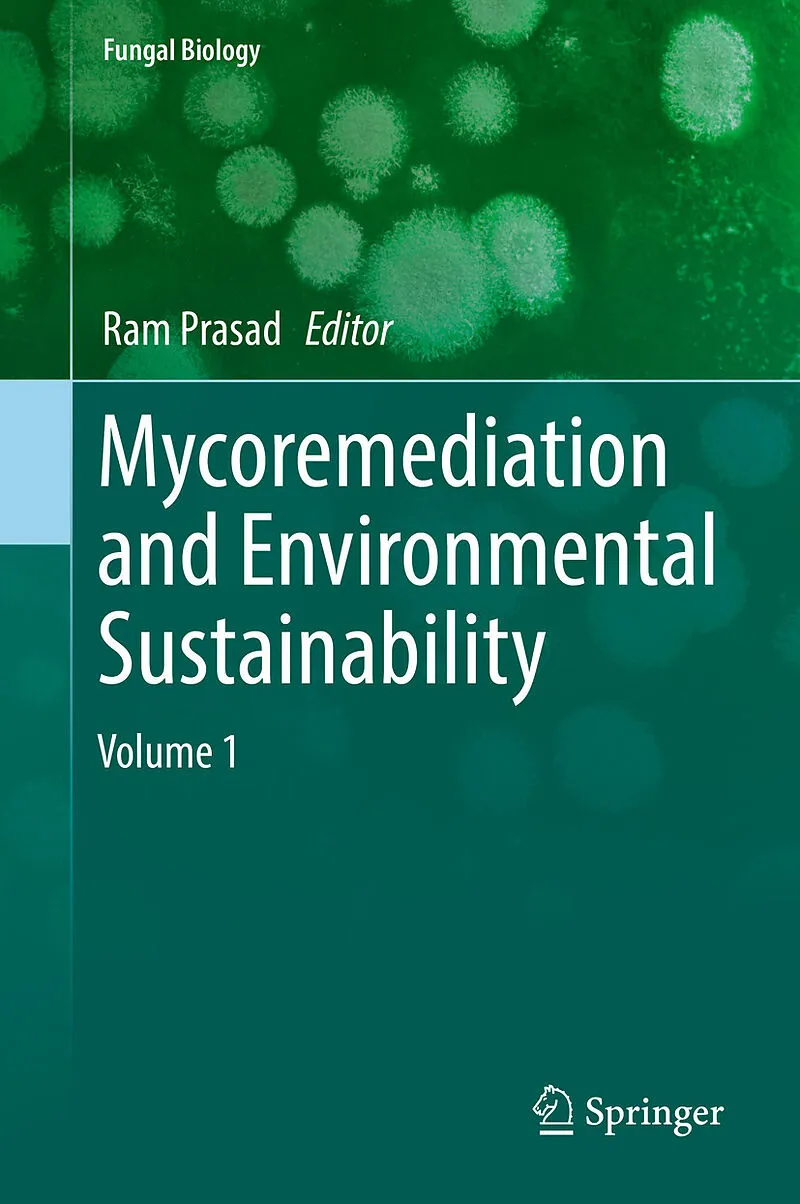

Beschreibung
Autorentext Ram Prasad is Assistant Professor at the Amity Institute of Microbial Technology, Amity University, Uttar Pradesh, India. Dr. Prasad completed his Ph.D. at the Department of Microbiology, Chaudhary Charan Singh University, Meerut, UP, India, in co...